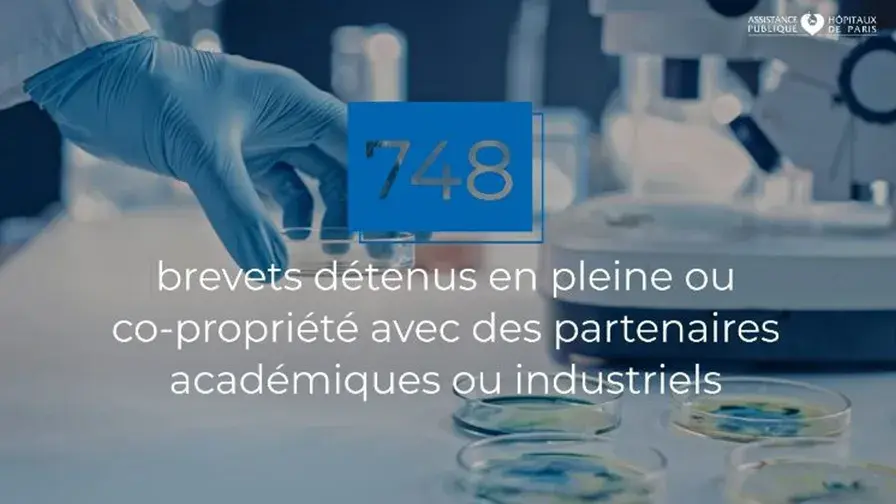
Les RDV Carnot 2022

Mis à jour le 10/02/2025
Retour en images sur les rdv Carnot 2022 : l’AP-HP au cœur de l’innovation
L’AP-HP était présente aux RDV Carnot, les rendez-vous de la R & D pour les entreprises organisés par le label Carnot, les 12 et 13 octobre.
Lors de ce salon, tous les acteurs de l’écosystème de l’innovation se sont rencontrés autour de tables rondes et de rendez-vous d’affaires entre porteurs de projets, promoteurs et entreprises start-up, PME et grands groupes.
Le label Carnot est un réseau de 39 instituts labellisés par l’ANR pour leur capacité à mener des projets de recherche partenariale pour l’innovation des entreprises. Ces 39 instituts rassemblent 35 000 professionnels de la recherche, soit 20 % des moyens humains de la recherche publique, et réalisent 55 % des contrats de R & D externalisés par les entreprises à la recherche publique.
« Les Rendez-vous Carnot, c’est pour nous l’occasion d’affirmer le rôle de l’AP-HP en tant que moteur de l’innovation en santé, à l’écoute des porteurs de projets et des entreprises », selon Erik Domain, directeur adjoint du Carnot@AP-HP.

